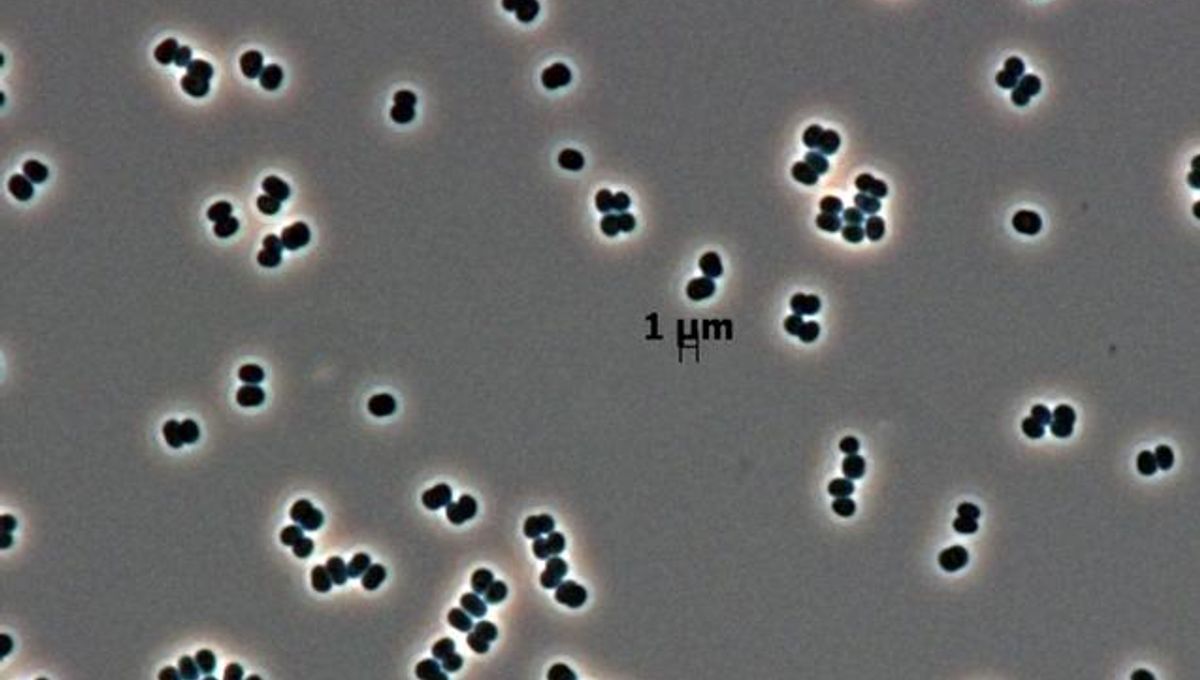
Feed Image

IFLScience
shared a link post in group #IFLScience
www.iflscience.com
Bacteria That Can Come Back From The Dead May Have Gone To Space: "They Are Playing Hide And Seek"
Extremely sturdy bacteria that only play dead may have hitched a ride on our spacecraft.
